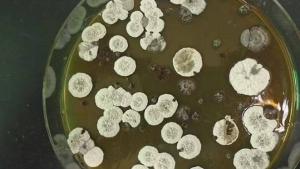

توصلت دراسة إلى أن بعض خلايا البكتيريا يمكن أن تصبح «جائعة» وسريعة الانفعال وتغضب، تماماً مثلها مثل البشر.
ووجد علماء الأحياء المجهرية أن نقص العناصر الغذائية يتسبب في إطلاق بعض الخلايا البكتيرية للسموم الضارة في أجسامنا والتي يمكن أن تجعلنا مرضى.
وبينما ركزت الدراسة الحالية على بكتيريا واحدة فقط، إلا أنه إذا كانت النتائج متطابقة مع الأنواع الأخرى، فقد يمهد هذا لعلاجات جديدة للعدوى، وفقاً للدراسة المنشورة في«Nature Microbiology».
وقد أجرى الدراسة عالم الأحياء الدقيقة البروفيسور آدم روزنتال من جامعة نورث كارولينا في تشابل هيل وزملاؤه من جامعتي هارفارد وبرينستون، بالإضافة إلى شركة دانيسكو لأغذية الحيوانات الأليفة الهولندية.
وقال البروفيسور روزنتال: «تتصرف البكتيريا بشكل مختلف كثيراً عما كنا نظن تقليدياً. حتى عندما ندرس مجتمعاً من البكتيريا المتماثلة جينياً، فإنها لا تتصرف جميعاً بالطريقة نفسها. وقد أردنا معرفة السبب». بحسب«روسيا اليوم».
ويسعى روزنتال وزملاؤه لتطبيق النتائج التي توصلوا إليها مؤخراً لمعالجة تحمل المضادات الحيوية. ويحدث تحمل المضادات الحيوية عندما تكون بعض البكتيريا قادرة على تفادي الهدف الدوائي حتى عندما لا يطور المجتمع طفرات لجعل جميع الخلايا مقاومة للمضادات الحيوية. ويمكن أن يؤدي هذا التحمل إلى علاج أقل فعالية، لكن الآليات التي تتحكم في قابلية التحمل ليست مفهومة جيداً.
ومع اكتمال دراستهم الأولية، يواصل الباحثون الآن دراستهم لسلوك هذه المجتمعات البكتيرية المعقدة.